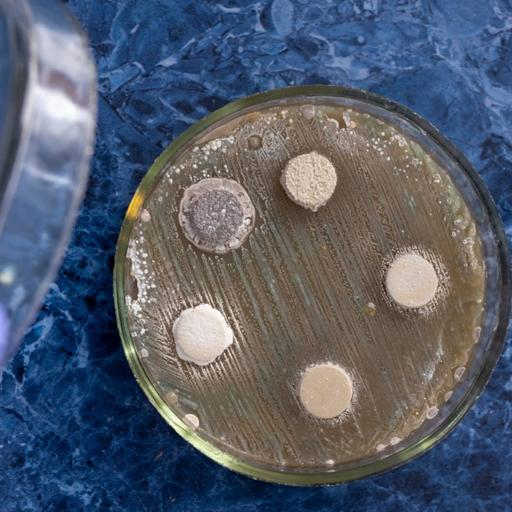
Picture of the product

Presentations | English
Cultivating bacteria or microbial culture is a method of multiplying bacteria by letting them reproduce in predetermined culture media under controlled laboratory conditions. These are used to determine the type of organism, its abundance in the sample being tested, or both. To accomplish this, one must know the food nutrients required and provide proper environmental conditions. There are three techniques for cultivation of bacteria:- a)Batch culture technique or the closed system of cultivation. b)Fed-batch culture technique or the semi-closed system of cultivation. c) Continuous culture technique or the open system of cultivation. The purpose of culturing is to estimate viable count, to test for antibiotic sensitivity, to create antigens for laboratory use, for certain genetic studies and manipulations of the cells etc. Please read the informative presentation on the topic.
25.00
Lumens
PPTX (50 Slides)
Presentations | English